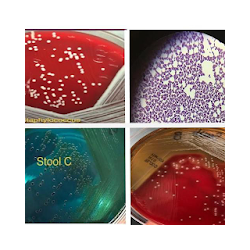

androidتحميل تطبيقات والعاب مهكرة ذات صلة بBioQuiz
تحميل العاب وتطبيقات الاندرويد المهكرة والبريميوم ذات صلة بBioQuiz for android المتجر العربي لمراجعة العاب تطبيقات الأندرويد، تحميل العاب بنات، العاب اكشن، العاب ذكاء Arabic Android Review Apps Catalog - الصفحة 2 for android.

علم الأحياء العام سؤال المعرفة والإجابة باللغة الهندية هذه التطبيقات تحتوي على مختلف مسألة المعرفة ...

باستخدام هذه الجزيئية لعبة الأحياء مسابقة تعلم، تنفق بعض الوقت الحر معها، والمتعة اللعب. لديها 3 أنو...

في هذا المسابقة عدد الأسئلة أكثر من 150+. يمكنك ممارسة المزيد من n أكثر. في كل مرة يتم تبديل الأسئلة...

في هذا المسابقة عدد الأسئلة من 200+. يمكنك ممارسة المزيد من n أكثر. في كل مرة يتم تبديل الأسئلة في ه...

لامتحانات 2024. كل شيء في مراجعة AQA GCSE Biology مع أكثر من 500 سؤال وفيديو وأوراق بحثية سابقة يعد...

في هذه المسابقة عدد الأسئلة هي 150+. يمكنك ممارسة أكثر أكثر N. وأسكن كل الأسئلة الوقت في هذا الاختبا...

في هذه المسابقة عدد الأسئلة هي 150+. يمكنك ممارسة أكثر أكثر N. وأسكن كل الأسئلة الوقت في هذا الاختبا...

في هذا المسابقة عدد الأسئلة من 100+. يمكنك ممارسة المزيد من n أكثر. في كل مرة يتم تبديل الأسئلة في ه...

لم الأحياء الكتاب الاليكتروني ومسابقة يعد eBook مفهومًا مبتكرًا من Sana Edutech يوفر مواد تعليمية ع...

في هذه المسابقة عدد الأسئلة هي 200+. يمكنك ممارسة أكثر أكثر N. وأسكن كل الأسئلة الوقت في هذا

التطبيق يسمح لك للبحث الكلمات Bailogy والاطلاع على تعريف لنفسه. الكيمياء قاموس والتعلم والتشاور فيم...

تطبيق رائع لمساعدتك على تعلم كيفية التعرف على الكائنات الحية الدقيقة غير معروفة وأنواع مختلفة من الب...

باستخدام هذه اللعبة تعلم Bioinformatics ، وقضاء بعض وقت الفراغ معها ، والمتعة تشغيله. لديها 3 أنواع ...

في هذه المسابقة عدد الأسئلة هي 150+. يمكنك ممارسة أكثر أكثر N. وأسكن كل الأسئلة الوقت في هذا الاختبا...

في هذه المسابقة عدد الأسئلة هي 200+. يمكنك ممارسة أكثر أكثر N. وأسكن كل الأسئلة الوقت في هذا الاختبا...

في هذا المسابقة عدد الأسئلة من 200+. يمكنك ممارسة المزيد من n أكثر. في كل مرة يتم تبديل الأسئلة في ه...
في هذا المسابقة عدد الأسئلة من 100+. يمكنك ممارسة المزيد من n أكثر. في كل مرة يتم تبديل الأسئلة في ه...